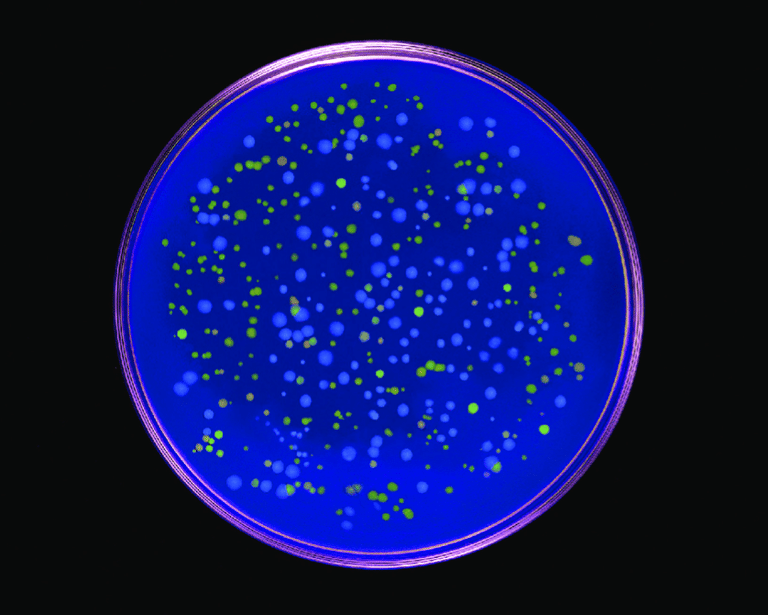
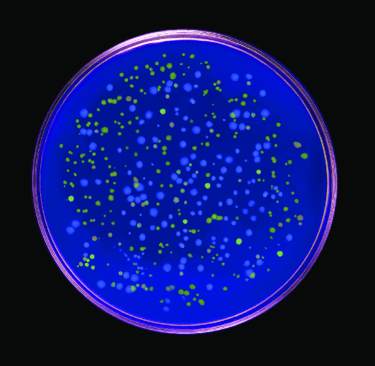

Eduardo Kac and His Piece 'Genesis'
Eduardo Kac's transgenic piece that centers on the intricate fusion of biology, belief systems, technology, dialogue, and ethics.
BIO ART
Sunskritha R Shivaprasad
3/17/20243 min read


Edaurdo Kac (born July 3, 1962) is a Brazilian and American contemporary artist who specializes in performance art, olfactory art, telecommunications art, space art, telepresence, interactive art, and bioart. He is well known for his space art and bioart, which revolves around the creation of transgenic life form, in which DNA of another species is introduced into an organism, to create new genetic traits. Consequently, he coined the term "Bio Art" in 1997 after he created his first bioart piece, 'Time Capsule' in 1997.
Two of his major works are the transgenic rabbit 'GFP Bunny' (a fluorescent rabbit), named ‘Alba’ (2000) and for his work ‘Natural History of the Enigma’, a genetically-engineered flower called ‘Edunia’ (2003/08), a petunia that contains his own DNA. His other works include ‘A-positive’ (1997), ‘Genesis’ (1999) ‘The Eighth Day’ (2001), ‘Move 36’ (2002/04), and ‘Specimen of Secrecy About Marvelous Discoveries’ (2004/06).
In Eduardo Kac’s TEDx Talk, Kac expressed that mankind has always aspired to create creatures as evidenced by ancient greek mythology, Amazonian folklore, Jewish traditions and other beliefs from Japan, Austria, and Germany. He intends to create artworks that shape life, create life, and engage with the material processes of life.
Eduardo Kac
A-positive | In this piece a dialogical exchange between a human being and a robot took place through two intravenous hookups.
His 1999 work 'Genesis' is a transgenic artwork that delves into the complex relationship between biology, belief systems, information technology, dialogical interaction, ethics, and the Internet. In this piece, Kac converted a sentence from the Bible Genesis to morse code. He used his own code to convert morse code into genetic code (A, T, G, and C). The code was then synthesized and integrated into bacteria. Kac essentially created organisms with text encoded into them. When these bacteria were placed on top of a UV light box, which could be activated remotely by participants all over the world, the encoded text could be changed. Thus, Kac devised a process of input, processing, and input, which we all do every day.
Kac's 'Genesis' was an ingenious fusion of biology, modern technology, and living organisms. By allowing global interaction with encoded text via UV light manipulation, Kac not only blurred the lines between art and science, but also challenged traditional notions of authorship in creation.


Coding of the genetic code (left) and decoding of the genetic code after exposure to UV light

GFP Bunny (2000) | Alba the genetically-modified rabbit containing GFP (green fluorescent protein) gene
Natural History of Enigms | Kac with his transgenic flowers, 'Edunia' (2003/08)
Genesis (1999) | A petri plate containing the transgenic bacteria
Genesis (1999)
Contacts
sunskrithas19@gmail.com
Blog
© TheArtGene
sunskrithas@theartgene.com
Subscribe to our blog!
Updates bi-weekly every Sunday!
